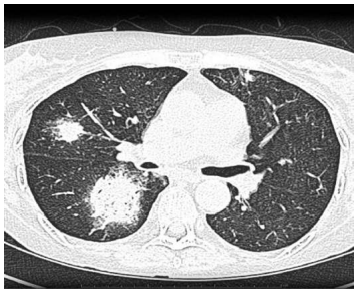
Enunciado 4939215-1

Foram encontradas 50 questões.
Caso clínico hipotético para a questão.
Um paciente masculino de 56 anos de idade, com leucemia
mieloide aguda em quimioterapia, tem apresentado febre
persistente há 5 dias, juntamente com tosse seca e dispneia.
Esses são sintomas refratários ao uso de meropenem e
vancomicina prescritos pela equipe de hematologia do
serviço médico. O paciente apresentou-se eupneico em ar
ambiente, normotenso, normocárdico, bem-perfundido e
sem alteração neurológica. Foi realizada uma TC de tórax,
que está disposta a seguir.

Provas
Questão presente nas seguintes provas
Caso clínico hipotético para a questão.
Um paciente masculino de 56 anos de idade, com leucemia
mieloide aguda em quimioterapia, tem apresentado febre
persistente há 5 dias, juntamente com tosse seca e dispneia.
Esses são sintomas refratários ao uso de meropenem e
vancomicina prescritos pela equipe de hematologia do
serviço médico. O paciente apresentou-se eupneico em ar
ambiente, normotenso, normocárdico, bem-perfundido e
sem alteração neurológica. Foi realizada uma TC de tórax,
que está disposta a seguir.
Provas
Questão presente nas seguintes provas
Paciente masculino, 65 anos de idade, com dispneia aguda
e hipotensão, é avaliado no pronto-socorro. O exame físico
sugere estado de hipoperfusão tecidual, mas a etiologia
permanece incerta. O POCUS revela veia cava inferior
colabada, ausência de líquido livre abdominal, pulmões sem
linhas B ou consolidações, e coração com contratilidade
global preservada, sem derrame pericárdico.
Com base nesse caso clínico hipotético, assinale a opção que contempla a hipótese diagnóstica mais provável.
Com base nesse caso clínico hipotético, assinale a opção que contempla a hipótese diagnóstica mais provável.
Provas
Questão presente nas seguintes provas
Mulher, 45 anos de idade, com quadro de leve cefaleia
frontal associado à rinorreia hialina, temperaturas aferidas
de 37,8 graus celsius, sem alergia medicamentosa,
apresenta piora dos sintomas após 5 dias de melhora inicial.
Com base nesse caso clínico hipotético, assinale a opção que contempla o critério clínico mais associado à infecção de etiologia bacteriana.
Com base nesse caso clínico hipotético, assinale a opção que contempla o critério clínico mais associado à infecção de etiologia bacteriana.
Provas
Questão presente nas seguintes provas
Paciente de 60 anos de idade, com perda de peso, astenia,
dor abdominal crônica e hiponatremia persistente.
Exames: cortisol matinal 3,2 µg/dL (VR > 5), ACTH elevado,
aldosterona baixa, renina aumentada.
Com base nesse caso clínico hipotético, assinale a opção que contempla a etiologia mais provável.
Com base nesse caso clínico hipotético, assinale a opção que contempla a etiologia mais provável.
Provas
Questão presente nas seguintes provas
Mulher de 60 anos de idade, com has e dm em tratamento
há 10 anos, doença renal crônica e hiperuricemia
recém-diagnosticada. Em uso de enalapril, dapaglifozina,
insulina e alopurinol. Inicia quadro de a febre, exantema,
edema facial, linfadenopatia e elevação de transaminases
com eosinofilia.
Com base nesse caso clínico hipotético, assinale a opção que contempla a conduta inicial prioritária.
Com base nesse caso clínico hipotético, assinale a opção que contempla a conduta inicial prioritária.
Provas
Questão presente nas seguintes provas
Equipe inicia ressuscitação em um paciente com taquicardia
ventricular sem pulso. Após 2 minutos de compressões e
desfibrilação, o ritmo persiste. Realizada nova desfibrilação
e administração de adrenalina. Paciente persiste em TV
após mais 2 minutos.
Com base nesse caso clínico hipotético, assinale a opção que contempla a intervenção farmacológica mais recomendada nesse momento.
Com base nesse caso clínico hipotético, assinale a opção que contempla a intervenção farmacológica mais recomendada nesse momento.
Provas
Questão presente nas seguintes provas
Um homem de 62 anos de idade, previamente hígido,
é admitido após 15 minutos de crises tônico-clônicas
generalizadas sem recuperação da consciência entre os
episódios. Glicemia capilar normal. Após administração de
diazepam IV, as crises persistem.
Com base nesse caso clínico hipotético, assinale a opção que contempla o próximo passo mais apropriado.
Com base nesse caso clínico hipotético, assinale a opção que contempla o próximo passo mais apropriado.
Provas
Questão presente nas seguintes provas
Um paciente de 68 anos de idade estava com insuficiência
cardíaca descompensada perfil B e pneumonia associada,
em uso de nitrato, hidralazina, carvedilol e furosemida ev.
Após 48 horas, apresentou fraqueza muscular, parestesias
e o ECG a seguir.

Com base nesse caso clínico hipotético, assinale a opção que apresenta o distúrbio hidroeletrolítico associado a esse quadro.

Com base nesse caso clínico hipotético, assinale a opção que apresenta o distúrbio hidroeletrolítico associado a esse quadro.
Provas
Questão presente nas seguintes provas
Um paciente de 52 anos de idade, que apresentava
obesidade, relatou pirose diária há 6 meses, regurgitação
ácida noturna e tosse crônica. Ele negou perda de peso ou
disfagia.
Com base nesse caso clínico hipotético, assinale a opção que apresenta a conduta adequada a se providenciar.
Com base nesse caso clínico hipotético, assinale a opção que apresenta a conduta adequada a se providenciar.
Provas
Questão presente nas seguintes provas
Cadernos
Caderno Container